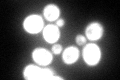
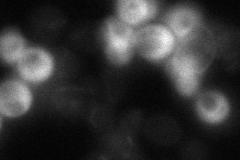
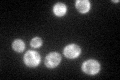

View description
Dual function protein involved in translation initiation as a substoichiometric component (eIF3j) of translation initiation factor 3 (eIF3) and required for processing of 20S pre-rRNA; binds to eIF3 subunits Rpg1p and Prt1p and 18S rRNA
Localization:
Intensity:
Fold change:
Significance:
-
C’ GFP library in SD
cytosol147.26 -
N' NOP1pr-GFP in SD

cytosol285.595 -
N' TEF2pr-mCherry in SD

cytosol388.125 -
N' NATIVEpr-GFP in SD
cytosol22.1471 -
N' TEF2pr-VC and Cyto-VN in SD

#N/A0 -
C’ GFP library in SD+DTT

cytosol164.671.11No -
C’ GFP library in SD+H2O2

cytosol148.451No -
C’ GFP library in Starvation Media
cytosol111.550.75No -
C’ GFP library on the background of Pup2-DaMP

cytosol -
C’ GFP library on the background of CCT mutant

cytosol122.1970.829734No
